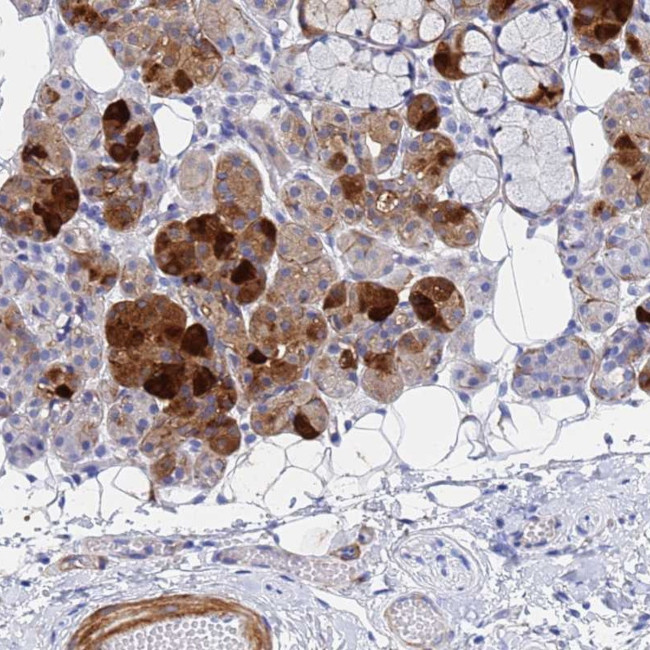
Cystatin 2 Antibody in Immunohistochemistry (Paraffin) (IHC (P))

Search
Invitrogen
Cystatin 2 Polyclonal Antibody
{{$productOrderCtrl.translations['antibody.pdp.commerceCard.promotion.promotions']}}
{{$productOrderCtrl.translations['antibody.pdp.commerceCard.promotion.viewpromo']}}
{{$productOrderCtrl.translations['antibody.pdp.commerceCard.promotion.promocode']}}: {{promo.promoCode}} {{promo.promoTitle}} {{promo.promoDescription}}. {{$productOrderCtrl.translations['antibody.pdp.commerceCard.promotion.learnmore']}}
产品信息
PA5-60476
种属反应
宿主/亚型
分类
类型
抗原
偶联物
形式
浓度
规格
纯化类型
保存液
内含物
保存条件
运输条件
RRID
产品详细信息
Immunogen sequence: EEDRIIEGGI YDADLNDERV QRALHFVIS
Highest antigen sequence identity to the following orthologs: Mouse - 38%, Rat - 38%.
靶标信息
The cystatin superfamily is a well-established family of cysteine protease inhibitors. Cystatins A and B (type 1) are mainly intracellular; cystatins C, D, E/M, F, G, S, SN and SA cystatins are extracellular (type 2); and the kininogens are type 3 cystatins which are intravascular proteins. All true cystatins inhibit cysteine peptidases of the papain family, such as cathepsins, and some also inhibit legumain family enzymes. Cystatin SA, cystatin S and cystatin SN are found primarily in saliva. Cystatin S and SN can also be expressed in tears, urine and seminal fluid. Cystatin C is a related protein which is expressed in brain, thymus, ovary, epididymis and vas deferens. Cystatin D protects against proteinases in the oral cavity, while Cystatin E/M and F moderate the inhibition of cathepsin proteins. The fetuins, part of the cystatin superfamily, are secretable proteins that influence osteogenesis and bone resorption, regulation of the insulin and hepatocyte growth factor receptors and the response to systemic inflammation. High molecular weight kininogen (Kininogen HC) and low molecular weight kininogen (Kininogen LC) have varied roles, though they both inhibit the thrombin- and plasmin-induced aggregation of thrombocytes.
仅用于科研。不用于诊断过程。未经明确授权不得转售。
篇参考文献 (0)
生物信息学
蛋白别名: cystatin 2; cystatin S5; Cystatin-2; Cystatin-S5; Cystatin-SA; cysteine-proteinase inhibitor; salivary cysteine (thiol) protease inhibitor
基因别名: CST2
UniProt ID: (Human) P09228
Entrez Gene ID: (Human) 1470